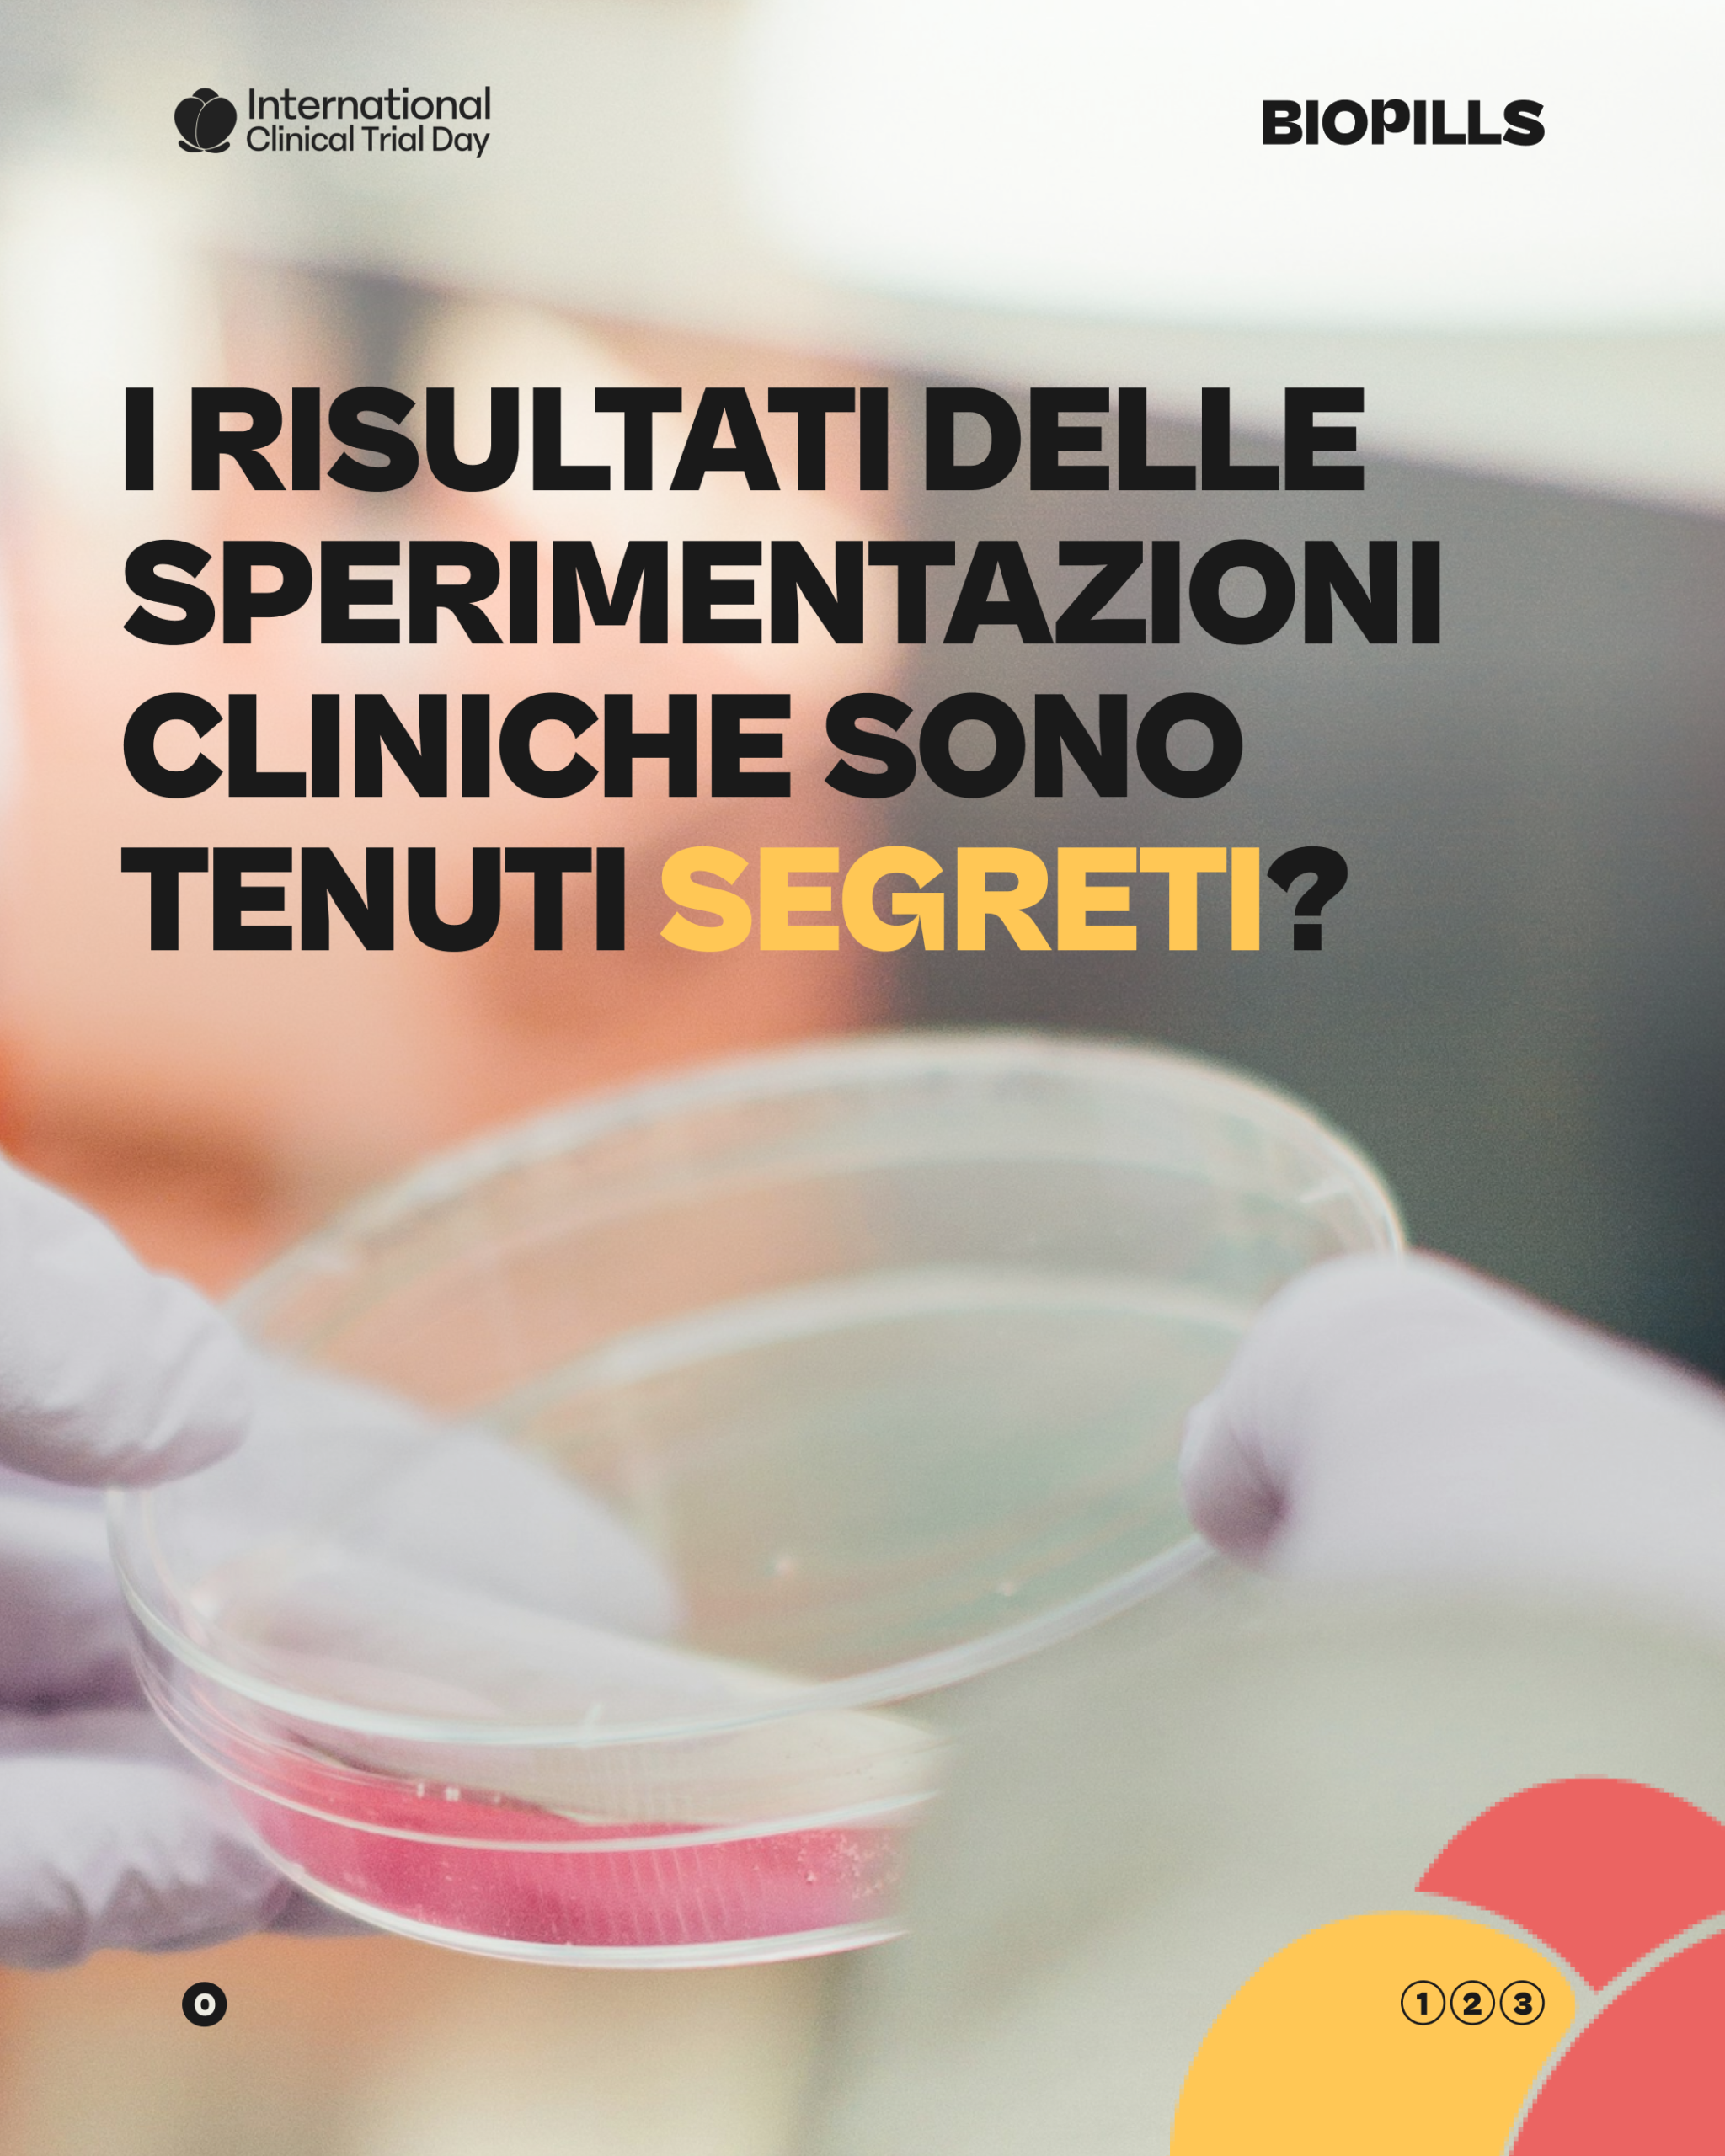

Recent Posts
- I risultati delle sperimentazioni cliniche sono tenuti segreti?
- “Non chiamatelo fare da cavia!” con Biopills
- Ma chi controlla i farmaci in commercio? con Chiara De Marchi
- Cosa sono gli studi randomizzati? con Chiara De Marchi
- Quali sono le persone che lavorano nella ricerca clinica? con Chiara De Marchi
- Perché è importante la Giornata della Sperimentazione Clinica? con Chiara De Marchi
- Parteciperesti ad uno studio clinico? con Chiara De Marchi